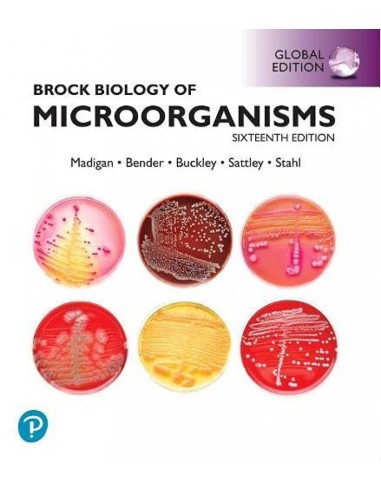
Brock biology of microorganisms
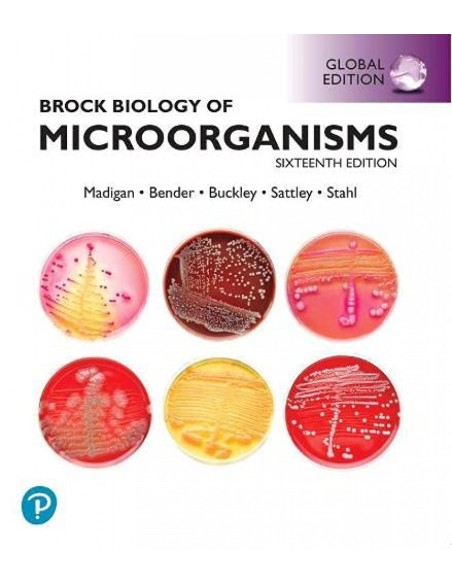
Brock biology of microorganisms

Carrito
No hay más artículos en su carrito
-
 Papelería
Oficina
Papelería
Oficina- Productos de embalaje
- Complementos de oficina
- Grapas
- Grapadoras de bolsillo
- Grapadoras de sobremesa
- Taladros de sobremesa
- Clips y chinchetas
- Anillas y encuadernadores
- Grapadoras, tenaza y clavadoras
- Quitagrapas
- Lupas
- Tampones y tintas
- Pinzas
- Portaclips
- Papeleras
- Cubiletes
- Grapadoras gran capacidad
- Expositores sobremesa
- Organizadores
- Grapadoras eléctricas
- Fechadores
- Sellos
- Almohadilla
- Sujetalibros
- Cajas de caudales
- Tarjetas
- Mojasellos y dediles
- Suministros para envíos
- Aparatos eléctricos de oficina
- Archivo y clasificación
- Fundas multitaladro y bolsas
- Separadores
- Dossiers
- Carpetas cartón con gomas
- Carpetas plástico con gomas
- Carpetas tipo sobre
- Carpetas clasificadoras
- Archivadores de palanca
- Carpetas plástico con anillas
- Archivador definitivo
- Subcarpetas
- índices separadores
- Carpetas de fundas
- Carpetas colgantes
- Bolsas multiusos
- Carpetas cartón con anillas
- Revisteros
- Bandejas sobremesa
- Carpetas portadocumentos
- Carpetas miniclip
- Ficheros sobremesa
- Archivadores en módulos
- Carpeptas proyectos
- Maletín portadocumentos
- CARPETA ANILLAS CON RECAMBIO
- Presentación
- Muebles de oficina
- Embalaje
- Máquinas de oficina
- Papel, sobres y equiquetas
- Ergonomía
Escolar- Colecciones
- Cuadernos, blocs y papel
- Cuadernos Lamela
- Cuadernos espiral tapa blanda
- Cuadernos espiral tapa dura
- Cuadernos tapa rígida
- Libretas
- Cuadernos espiral tapa extradura
- Cuadernos espiral tapa polipropileno
- Blocs de dibujo
- Blocs de notas
- Blocs de exámenes
- Blocs de música
- Recambios y resmillería
- Talonarios
- Rollos de sumadora
- Cuadernos del profesorado
- Fichas
- Tacos de notas
- Blocs de trabajos manuales
- Blocs de notas reposicionables
- Libros de contabilidad
- Cuadernos expositores
- Marcapáginas autoadhesivas
- Corte y adhesivos
- Escritura y corrección
- Correctores en cinta
- Rotuladores y lápices fluorescentes
- Portaminas
- Minas
- Lápices
- Gomas de borrar
- Rotuladores especiales
- Rotuladores para CD/DVD
- Rotuladores permanentes
- Bolígrafos y rollers
- Afilalápices
- Rotuladores de pizarra blanca
- Correctores lápiz/bolígrafo
- Correctores líquido
- Rotuladores de fibra
- Afilaborra
- Plumas
- Recambios y accesorios
- Rotuladores para textil
- Rotuladores para cartelería
- Rotuladores de tiza líquida
- Escritura estuchada
- Rotuladores multisuperficie
- Rotuladores acuerables
- Vades escolares
- Dibujo y pintura
- Mapas
- Manualidades
- Flautas
- Láminas didácticas
- Forro para libros
- Otros artículos escolares
Artes, manualidades y costura- Artículos básicos de manualidades
- Suministros para pintura, dibujo y arte
- Pinturas para cara y cuerpo
- Temperas
- Libros y páginas para colorear
- Pinceles para bellas artes
- Pinturas para manualidades
- Papel decorativo
- Pizarras de caballete
- Pasteles
- Tintas de dibujo
- Transferencias de imágenes
- Pintura lavable para pintar con dedos
- Pinceles de punta de silicona
- Difuminos
- Lienzos
- Paletas de pintura
- Baberos para pintura
- Maniquíes de dibujo
- Cajas de pinturas para bellas artes
- Paletas de óleo
- Pinturas al óleo
- Diluyentes y aditivos para pinturas
- Barnices decorativos
- Tableros de dibujo
- Botes de agua para pintura
- Esponjas para pintar
- Suministros para cerámica, alfarería y escultura
- Cartulinas y cintas para manualidades
- Coser, tejer y hacer ganchillo
- Manualidades, libros de recortes y estampación
- Kits de arte y manualidades
- Manualidades con madera
- Artículos para fiestas
- Organización, almacenamiento y transporte de suministros de arte y manualidades
- Fabricación de adornos con abalorios y bisutería
- Herramientas de corte para manualidades
- Artesanía En Madera
- Fabricación De Abalorios Y Bisutería
Puzzles, juegos y juguetes- Juguetes
- Muñecas
- Figuras de acción y coleccionables
- Juguetes de construcción
- Juguetes de peluche
- Juguetes de arte y manualidades
- Juguetes electrónicos
- Pegatinas y libros de pegatinas
- Sets de juguetes
- Figuras de juguete para niños
- Casas de juguete
- Juguetes interactivos
- Juguetes de habilidades motoras
- Juguetes de primera edad
- Juegos de rol
- Juguetes educativos y didácticos
- Armas de juguete
- Vehículos de juguete
- Juegos
- Juegos educativos
- Juegos de observación
- Juegos de matemáticas
- Juegos de lenguaje
- Juegos de ingenio
- Juegos de habilidad
- Juegos de cartas
- Juegos de mesa
- Juegos de magia
- Juegos magnéticos
- Juegos de idiomas
- Juegos de música
- Juegos de lógica
- Juegos de destreza
- Juegos de construcción
- Juegos de ciencias y experimentación
- Puzzles y rompecabezas
- Complementos para juegos
- JUEGOS
-
 Librería
Infantil y juvenil
Librería
Infantil y juvenil- Literatura infantil: de 0 a 2 años
- Literatura infantil: de 3 a 4 años
- Literatura infantil: de 5 a 6 años
- Literatura infantil: de 7 a 9 años
- Literatura infantil: de 10 a 12 años
- Literatura infantil: de 0 a 12 años
- Literatura juvenil: más de 12 años
- Literatura juvenil: más de 13 años
- Literatura juvenil: más de 15 años
- Poesía infantil/juvenil
- Teatro infantil/juvenil
- Novela gráfica
- Cómic y juegos
- Álbumes ilustrados
- Actividades, manualidades y pasatiempos
-
 Fotografía
Cámaras
Fotografía
Cámaras- Cámaras réflex digitales
- Cámaras web
- Cámaras con impresión instantánea
- Cámaras para deportes de acción
- Cámaras de documentos
- Videocámaras
- Cámaras de 360 grados
- Accesorios para cámaras web
- Drones con cámara
- Accesorios y suministros para cámaras fotográficas
- Trípodes
- Correas
- Accesorios para montaje de cámaras
- Cables para cámaras fotográficas
- Lentes de cámara
- Estuches para cámaras fotográficas
- Fundas para objetivos de cámaras
- Baterías para cámara/grabadora
- Empuñaduras con batería para cámara digital
- Marcos de fotos digitales y accesorios
- Películas instantáneas
- Flashes fotográficos
- Tapas para lentes
- Lentes para cámara fotográfica, adaptadores
- Mandos a distancia para cámaras
- Kits para cámaras
- Carcasas para cámaras
- Transmisores de datos de cámara
- Accesorios para cámara de deportes de acción
- Papel fotográfico
- Cámaras De Película
Equipos técnicos de audio y video- Distribución y procesamiento de señales
- Amplificadores de audio
- Convertidores de señal de vídeo
- Audio/vídeo extendedores
- Divisores de vídeo
- Dispositivos para capturar video
- Matrices de conmutación
- Divisores de audio
- Conmutadores de vídeo
- Generador de video de prueba
- Convertidores de audio
- Receptores AV
- Escaladores de vídeo
- Controladores de sistemas audiovisuales
- Grabadoras de audio digitales
- Mezcladores de vídeo
- Amplificadores de línea de video
- Distribuidores de vídeo
- Emuladores EDID
- Monitores De Audio
- Aisladores De Bucle De Tierra
- Componentes de audio doméstico
Accesorios para equipos de audio y video- Accesorios y piezas para equipos de audio doméstico
- Mandos a distancia y accesorios
- Micrófonos y accesorios
- Componentes y accesorios para televisores
- Antenas y accesorios
- Accesorios y piezas para auriculares y equipos de audio portátiles
- Accesorios y piezas para proyectores
- Piezas de repuesto para equipos audiovisuales
- Accesorios y piezas para sistemas de distribución y procesamiento de señales
- Accesorios y piezas para equipos de karaoke y Dj
-
 Informática
Ordenadores
Informática
Ordenadores- Ordenadores portátiles
- Servidores
- Pcs/estaciones de trabajo
- Ordenadores todo en uno (All-in-one Pcs)
- Ordenadores empotrados
- Ordenadores móviles de mano
- Clientes livianos
- Hardware para puntos de venta
- Software
- Licencias y actualizaciones de software
- Software de seguridad
- Software de comunicaciones
- Software de redes
- Software de gestión de documentos
- Software de infraestructura de TI
- Sistemas operativos
- Software de gestión empresarial
- Software de desarrollo
- Software multimedia
- Software de utilidades de Pc
- Software de etiquetado y códigos de barras
- Soluciones en la nube
- Software De Videovigilancia
- Accesorios para ordenadores
Accesorios de informática- Componentes
- Componentes de chasis
- Componentes de la interfaz
- Componentes de sistemas
- Soportes
- Estaciones dock para móviles
- Fundas para dispositivos periféricos
- Soportes y monturas para estaciones de trabajo/ PC todo en uno
- Soportes para CPU
- Accesorios para estaciones de base de carga de dispositivos móviles
- Herramientas para reparación de dispositivo electrónico
- Kits multimedia
- Accesorios y piezas para soportes
- Vinilos para dispositivos móviles
- Decodificadores
- Baterías y fuentes de alimentación
- Unidades de fuentes de alimentación
- Pilas domésticas
- Cargador de dispositivos móviles
- Baterías para sistemas UPS
- Baterías externas
- Adaptadores e inversores de corriente
- Unidades de distribución de energía (Pdus)
- Stick Pcs
- Sistemas de alimentación ininterrumpidas (UPS)
- Accesorios para UPS
- Cargadores de batería
- Receptores de carga inalámbrica para dispositivos móviles
- Armarios para baterías (SAI)
- Carritos y armarios de dispositivos portátiles
- Estaciones de energía portátiles
- Paneles de bypass de mantenimiento
- Accesorios Para Estaciones De Carga Portátiles
- Medidor De Energía Y Batería
- Impresoras y escáneres
- Redes
- Almacenamiento
- Dispositivos de entrada
- Alfombrillas para ratón
- Punteros inalámbricos
- Ratones
- Teclados
- Interruptores KVM
- Teclados para móviles
- Tabletas gráficas
- Teclados numéricos
- Descansa muñecas
- Accesorios de dispositivos de entrada
- Otros dispositivos de entrada
- Accesorios para tabletas gráficas
- Tablets de escritura
- Extensores KVM
- Paneles táctiles
- Lápiz óptico
- Interruptores De Teclado
- Monitores y accesorios
- Cables para computadoras y periféricos (1)
- Cables coaxiales
- Cables de red
- Cables VGA
- Cables de transmisión
- Cables USB
- Cables de conectores lightning
- Adaptadores de cable de vídeo
- Cambiadores de género para cables
- Cables de audio
- Cables HDMI
- Cables DVI
- Cables displayport
- Cables seriales
- Cables de SATA
- Cables de alimentación interna
- Conectores
- Cables para video, teclado y ratones (Kvm)
- Cables para computadoras y periféricos (2)
- Cables EUROCONECTORES
- Cables planos
- Accesorios para cables
- Cables de infiniband
- Divisores o combinadores de cables
- Cables S-Vídeo
- Cables de vídeo compuesto
- Cables USB internos
- Cables firewire
- Adaptadores de fibra óptica
- Cables de señal
- Cables Ps/2
- Cables paralelos
- Cables de fibra óptica e infiniband
- Cables de conexión de serie SCSI (SAS)
- Cables thunderbolt
Telefonía y comunicaciones- Teléfonos móviles inteligentes
- Teléfonos móviles
- Teléfonos
- Teléfonos IP
- Accesorios para equipos de telecomunicaciones
- Equipos de navegación
- Equipos de conferencias
- Altavoz
- Pantallas para salas de reuniones
- Sistemas de videoconferencia
- Altavoces bluetooth manos libres
- Sistemas de presentación inalámbricos
- Sistema de adminstración de llamadas
- Cámaras de videoconferencia
- Consolas para control de cámaras de videoconferencia
- Teléfonos para conferencias
- Monitores para videoconferencias
- Sistemas de audio para conferencias
- Consolas para sala de reuniones
- Accesorios para equipos de conferencias
- Equipo De Teleconferencia
- Puentes De Audioconferencias
- Equipos de radiocomunicación
Dispositivos electrónicos portátiles- Tabletas
- Tabletas infantiles
- Lápiz digital
- Lectores de libros electrónicos (E-books)
- Tabletas de firma digital
- Accesorios para dispositivos móviles
- Accesorios para lápiz digital
- Fundas para tablets
- Protectores de pantalla para tabletas
- Soportes de seguridad para tabletas
- Fundas para libros electrónicos (E-books)
- Piezas de repuesto para ordenadores de bolsillo tipo PDA
- Accesorios y piezas de recambio para tabletas
- Accesorios para fundas de tabletas
- Accesorios para lectores de libros electrónicos
Hogar y salud- Seguridad y automatización para el hogar
- Control de clima
- Pequenos electrodomésticos
- Electrodomésticos para bebidas
- Accesorios y piezas para pequeños electrodomésticos de cocina
- Electrodomésticos para repostería y cocina
- Exprimidores y prensas
- Batidoras y robots de cocina
- Electrodomésticos para la elaboración de postres y aperitivos
- Juego de ollas eléctricas
- Electrodomésticos de cocina especializados
- Utensilios para la preparación de alimentos
- Electrodomésticos grandes
- Herramientas para el jardín
- Coser y planchar
Español
EUR €
Brock biology of microorganisms
PEARSON-PRENTICE HALL
778342
Últimas unidades en stock
86,43 €
Impuestos incluidos